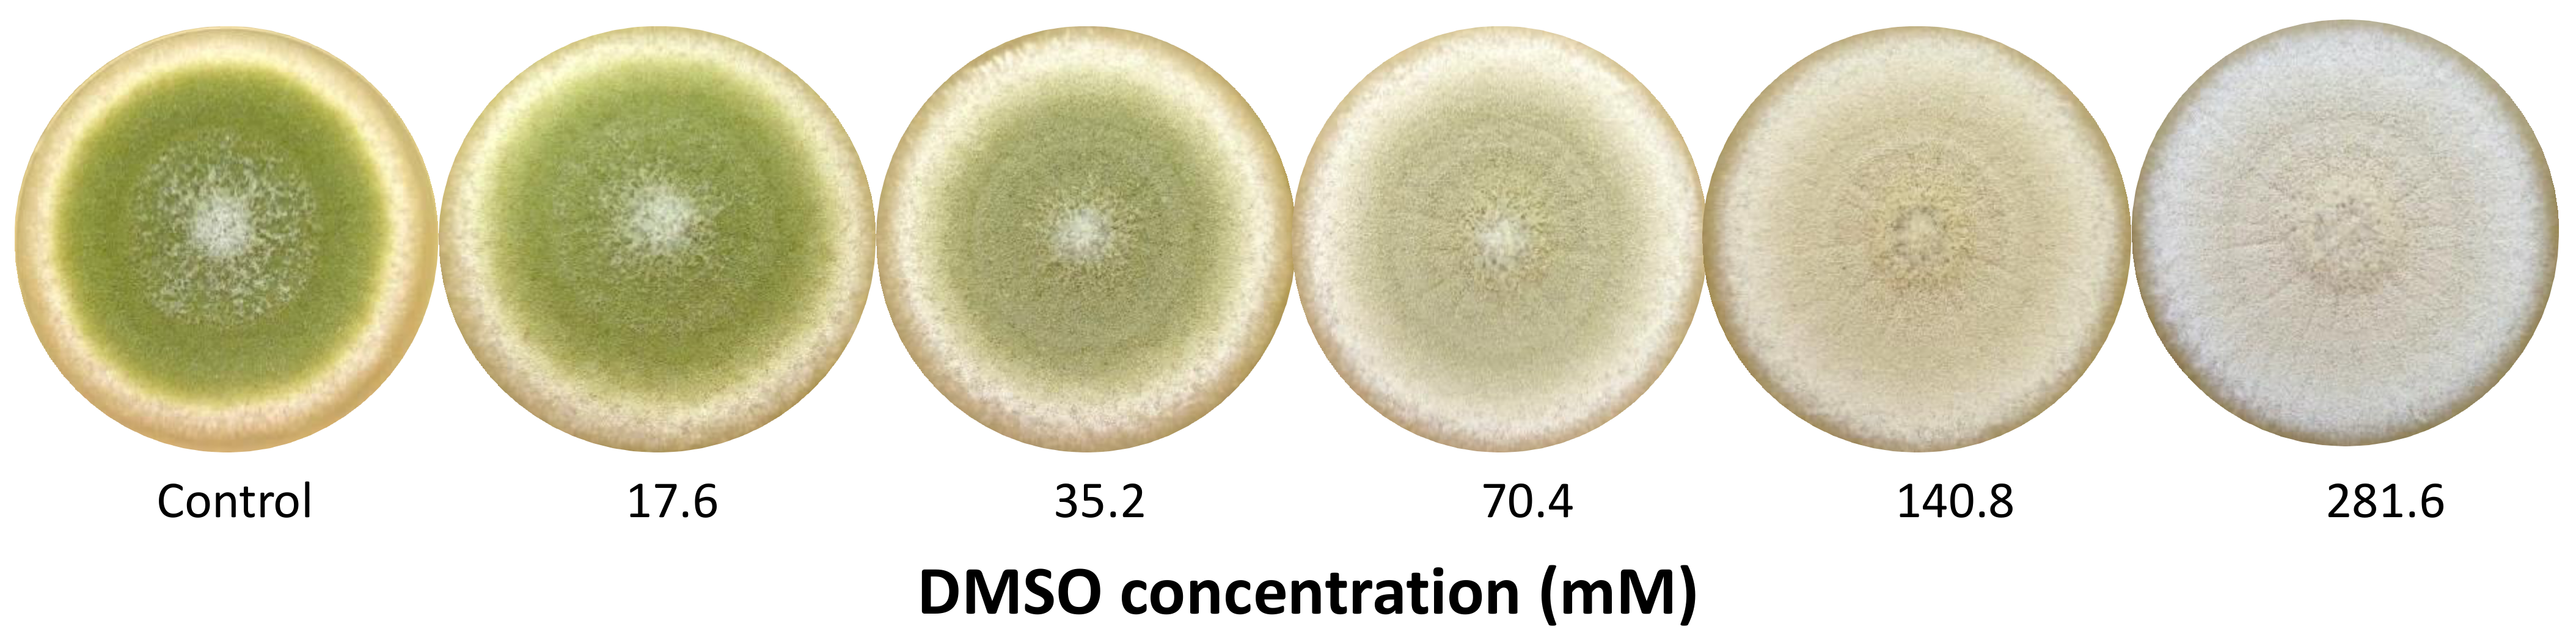
Jof 07 01055 g001

The Solvent Dimethyl Sulfoxide Affects Physiology, Transcriptome and Secondary Metabolism of Aspergillus flavus
Abstract
:1. Introduction
2. Materials and Methods
2.1. Chemicals and Reagents
2.2. Fungal Strain and Culture Conditions
2.3. Physiological Assays
2.3.1. Fungal Growth and Sporulation
2.3.2. Germination
2.3.3. Spore Resistance
2.4. Transcriptomic Study
2.4.1. RNA Extraction
2.4.2. RNA-Sequencing
2.4.3. Bioinformatic and Biostatistic Data Analysis
2.4.4. Functional Analysis
2.4.5. Expression Analysis of Secondary Metabolites Clusters
2.5. Secondary Metabolites Production Analysis
2.5.1. Aflatoxin B1 by HPLC-FLD
2.5.2. Other Studied Secondary Metabolites by Mass Spectrometry
2.6. Statistical Analysis
3. Results
3.1. Dose-Dependent Effect of DMSO on Pigmentation
3.2. Effect of DMSO on Physiological Parameters (Fungal Growth, Sporulation, Germination and Spore Resistance)
3.3. Transcriptomic Response of Aspergillus flavus to DMSO Treatment
3.4. Functional Analysis of Differentially Expressed Genes
3.5. Effect of DMSO Treatment on Secondary Metabolism
3.5.1. DMSO Impact on All Secondary Metabolism Gene Clusters
3.5.2. DMSO Impact on Characterized Secondary Metabolites (Cluster and Production)
- Aflatoxin B1
- Cyclopiazonic Acid
- Ustiloxin B
- Mixed regulated BGC: leporins, ditryptophenaline and kojic acid
3.6. Impact of DMSO Treatment on Expression of Genes Related to Fungal Development
3.6.1. Velvet Complex Members and Other Global Transcription Factors
3.6.2. Asexual Development and Pigmentation
4. Discussion
5. Conclusions
Supplementary Materials
Author Contributions
Funding
Institutional Review Board Statement
Informed Consent Statement
Data Availability Statement
Acknowledgments
Conflicts of Interest
References
- Capriotti, K.; Capriotti, J.A. Dimethyl sulfoxide: History, chemistry, and clinical utility in dermatology. J. Clin. Aesthet. Dermatol. 2012, 5, 24–26. [Google Scholar] [PubMed]
- Pearson, T.W.; Dawson, H.J.; Lackey, H. Natural occurring levels of dimethyl sulfoxide in selected fruits, vegetables, grains, and beverages. J. Agric. Food. Chem. 1981, 29, 1089–7091. [Google Scholar] [CrossRef] [PubMed]
- Galvao, J.; Davis, B.; Tilley, M.; Normando, E.; Duchen, M.R.; Cordeiro, M.F. Unexpected low-dose toxicity of the universal solvent DMSO. FASEB J. 2014, 28, 1317–1330. [Google Scholar] [CrossRef]
- Madruga, G.; Crivellenti, L.Z.; Borin-Crivellenti, S.; Cintra, C.A.; Gomes, L.G.; Spiller, P.R. Comparative use of dimethyl sulphoxide (DMSO) in different animal species. Vet. Med. 2017, 62, 179–185. [Google Scholar] [CrossRef] [Green Version]
- Penazzi, L.; Lorengel, J.; Sündermann, F.; Golovyashkina, N.; Marre, S.; Mathis, C.M.B.; Lewejohann, L.; Brandt, R.; Bakota, L. DMSO modulates CNS function in a preclinical Alzheimer’s disease model. Neuropharmacology 2017, 113, 434–444. [Google Scholar] [CrossRef] [PubMed] [Green Version]
- Santos, N.C.; Figueira-Coelho, J.; Martins-Silva, J.; Saldanha, C. Multidisciplinary utilization of dimethyl sulfoxide: Pharmacological, cellular, and molecular aspects. Biochem. Pharmacol. 2003, 65, 1035–1041. [Google Scholar] [CrossRef]
- Ansel, H.C.; Norred, W.P.; Roth, I.L. Antimicrobial activity of dimethyl sulfoxide against Escherichia coli, Pseudomonas aeruginosa and Bacillus megaterium. J. Pharm. Sci. 1969, 58, 836–838. [Google Scholar] [CrossRef] [PubMed]
- Randhawa, M.A.; Hamad, S.; Aljabre, M. Dimethyl Sulfoxide (DMSO) has an Additive Effect and Alters Minimal Inhibitory Concentrations of Antifungal Drugs. J. Rawalpindi Med. Coll. 2007, 11, 54–60. [Google Scholar]
- Hazen, K.C. Influence of DMSO on antifungal activity during susceptibility testing in vitro. Diagn. Microbiol. Infect. Dis. 2013, 75, 60–63. [Google Scholar] [CrossRef] [PubMed]
- Kim, J.H.; Yu, J.; Mahoney, N.; Chan, K.L.; Molyneux, R.J.; Varga, J.; Bhatnagar, D.; Cleveland, T.E.; Nierman, W.C.; Campbell, B.C. Elucidation of the functional genomics of antioxidant-based inhibition of aflatoxin biosynthesis. Int. J. Food Microbiol. 2008, 122, 49–60. [Google Scholar] [CrossRef]
- Lin, J.Q.; Zhao, X.X.; Zhi, Q.Q.; Zhao, M.; He, Z.M. Transcriptomic profiling of Aspergillus flavus in response to 5-azacytidine. Fungal Genet. Biol. 2013, 56, 78–86. [Google Scholar] [CrossRef] [PubMed]
- Li, H.; Shen, Q.; Zhou, W.; Mo, H.; Pan, D.; Hu, L. Nanocapsular Dispersion of Cinnamaldehyde for Enhanced Inhibitory Activity against Aflatoxin Production by Aspergillus flavus. Molecules 2015, 20, 6022–6032. [Google Scholar] [CrossRef] [PubMed] [Green Version]
- Yazdani, D.; Mior Ahmad, Z.A.; Yee How, T.; Jaganath, I.B.; Shahnazi, S. Inhibition of aflatoxin biosynthesis in Aspergillus flavus by phenolic compounds extracted of Piper betle L. Iran J. Microbiol. 2013, 5, 428–433. [Google Scholar] [PubMed]
- Grintzalis, K.; Vernardis, S.I.; Klapa, M.I.; Georgiou, C.D. Role of oxidative stress in sclerotial differentiation and aflatoxin B1 biosynthesis in Aspergillus flavus. Appl. Environ. Microbiol. 2014, 80, 5561–5571. [Google Scholar] [CrossRef] [PubMed] [Green Version]
- Amaike, S.; Keller, N.P. Aspergilus flavus. Annu. Rev. Phytopathol. 2011, 49, 107–133. [Google Scholar] [CrossRef]
- Varga, J.; Baranyi, N.; Chandrasekaran, M.; Vágvölgyi, C.; Kocsubé, S. Mycotoxin producers in the Aspergillus genus: An update. Acta Biol. Szeged. 2015, 59, 151–167. [Google Scholar]
- Schrenk, D.; Bignami, M.; Bodin, L.; Chipman, J.K.; del Mazo, J.; Grasl-Kraupp, B.; Hogstrand, C.; Hoogenboom, L.R.; Leblanc, J.C.; Nebbia, C.S.; et al. Risk assessment of aflatoxins in food. EFSA J. 2020, 18, e06040. [Google Scholar] [CrossRef]
- European Union. Commission regulation 1881/2006 setting maximum levels of certain contaminants in foodstuffs. Off. J. Eur. Un. 2006, 2006, L364. [Google Scholar]
- FDA. Compliance Policy Guide Sec. 683.100 Action Levels for Aflatoxins in Animal Food; Food and Drug Administration: Silver Spring, MD, USA, 2019. [Google Scholar]
- FDA. Compliance Policy Guide Sec. 555.400 Aflatoxins in Human Food; Food and Drug Administration: Silver Spring, MD, USA, 2021. [Google Scholar]
- Nierman, W.C.; Yu, J.; Fedorova-Abrams, N.D.; Losada, L.; Cleveland, T.E.; Bhatnagar, D.; Bennett, J.W.; Dean, R.; Payne, G.A. Genome Sequence of Aspergillus flavus NRRL 3357, a strain that causes aflatoxin contamination of food and feed. Genome Announc. 2015, 3, 4–5. [Google Scholar] [CrossRef] [PubMed] [Green Version]
- Sharma, A.; Sharma, K. Should Solubility and Zone of Inhibition Be the Only Criteria for Selection of Solvent in Antimicrobial Assay? Adv. Biol. Res. 2011, 5, 241–247. [Google Scholar]
- Carley, H.E.; Watson, R.D.; Huber, D.M. Inhibition of Pigmentation in Aspergillus niger by Dimethylsulfoxide. Can. J. Bot. 1967, 45, 1451–1453. [Google Scholar] [CrossRef]
- Bean, G.A.; Rambo, G.W.; Klarman, W.L. Influence of dimethyl sulfoxide (DMSO) on conidial pigmentation and consequent UV light sensitivity of aflatoxin producing strains of Aspergillus flavus. Life Sci. 1969, 8, 1185–1191. [Google Scholar] [CrossRef]
- Mahgubi, A.E.; Puel, O.; Bailly, S.; Tadrist, S.; Querin, A.; Ouadia, A.; Oswald, I.P.; Bailly, J.D. Distribution and toxigenicity of Aspergillus section Flavi in spices marketed in Morocco. Food Control 2013, 32, 143–148. [Google Scholar] [CrossRef]
- Bluma, R.V.; Amaiden, M.R.; Etcheverry, M. Screening of Argentine plant extracts: Impact on growth parameters and aflatoxin B1 accumulation by Aspergillus section Flavi. Int. J. Food Microbiol. 2008, 122, 114–125. [Google Scholar] [CrossRef] [PubMed]
- Gougouli, M.; Koutsoumanis, K.P. Modeling germination of fungal spores at constant and fluctuating temperature conditions. Int. J. Food Microbiol. 2012, 152, 153–161. [Google Scholar] [CrossRef] [PubMed]
- Levdansky, E.; Kashi, O.; Sharon, H.; Shadkchan, Y.; Osherov, N. The Aspergillus fumigatus cspA gene encoding a repeat-rich cell wall protein is important for normal conidial cell wall architecture and interaction with host cells. Eukaryot. Cell 2010, 9, 1403–1415. [Google Scholar] [CrossRef] [PubMed] [Green Version]
- Caceres, I.; El Khoury, R.; Medina, Á.; Lippi, Y.; Naylies, C.; Atoui, A.; El Khoury, A.; Oswald, I.P.; Bailly, J.D.; Puel, O. Deciphering the Anti-Aflatoxinogenic Properties of Eugenol Using a Large-Scale q-PCR Approach. Toxins 2016, 8, 123. [Google Scholar] [CrossRef] [Green Version]
- El Khoury, R.; Caceres, I.; Puel, O.; Bailly, S.; Atoui, A.; Oswald, I.P.; El Khoury, A.; Bailly, J.D. Identification of the Anti-Aflatoxinogenic Activity of Micromeria graeca and Elucidation of Its Molecular Mechanism in Aspergillus flavus. Toxins 2017, 9, 87. [Google Scholar] [CrossRef] [PubMed] [Green Version]
- Caceres, I.; El Khoury, R.; Bailly, S.; Oswald, I.P.; Puel, O.; Bailly, J.D. Piperine inhibits Aflatoxin B1 production in Aspergillus flavus by modulating fungal oxidative stress response. Fungal Genet. Biol. 2017, 107, 77–85. [Google Scholar] [CrossRef]
- Edgar, R.; Domrachev, M.; Lash, A.E. Gene Expression Omnibus. NCBI gene expression and hybridization array data repository. Nucleic Acids Res. 2002, 30, 207–210. [Google Scholar] [CrossRef] [PubMed] [Green Version]
- Krueger, F. Trim Galore! A Wrapper Tool around Cutadapt and FastQC to Consistently Apply Quality and Adapter Trimming to FastQ files, with Some Extra Functionality for MspI-Digested RRBS-Type (Reduced Representation Bisufite-Seq) Libraries. 2015. Available online: https://www.bioinformatics.babraham.ac.uk/projects/trim_galore (accessed on 9 December 2021).
- Liao, Y.; Smyth, G.K.; Shi, W. FeatureCounts: An efficient general-purpose program for assigning sequence reads to genomic features. Bioinformatics 2014, 30, 923–930. [Google Scholar] [CrossRef] [PubMed] [Green Version]
- R Development Core Team. R: A Language and Environment for Statistical Computing; R Foundation for Statistical Computing: Vienna, Austria, 2008; Available online: http://www.r-project.org/ (accessed on 9 December 2021).
- Robinson, M.D.; McCarthy, D.J.; Smyth, G.K. edgeR: A Bioconductor package for differential expression analysis of digital gene expression data. Bioinformatics 2010, 26, 139–140. [Google Scholar] [CrossRef] [Green Version]
- Benjamini, Y.; Hochberg, Y. Controlling the False Discovery Rate: A Practical and Powerful Approach to Multiple Testing. J. R. Stat. Soc. Ser. B Stat. Methodol. 1995, 57, 289–300. [Google Scholar] [CrossRef]
- Stajich, J.E.; Harris, T.; Brunk, B.P.; Brestelli, J.; Fischer, S.; Harb, O.S.; Kissinger, J.C.; Li, W.; Nayak, V.; Pinney, D.F.; et al. FungiDB: An integrated functional genomics database for fungi. Nucleic Acids Res. 2012, 40, 675–681. [Google Scholar] [CrossRef] [PubMed]
- Supek, F.; Bošnjak, M.; Škunca, N.; Šmuc, T. Revigo summarizes and visualizes long lists of gene ontology terms. PLoS ONE 2011, 6, e21800. [Google Scholar] [CrossRef] [Green Version]
- Georgianna, D.R.; Fedorova, N.D.; Burroughs, J.L.; Dolezal, A.L.; Bok, J.W.; Horowitz-Brown, S.; Woloshuk, C.P.; Yu, J.; Keller, N.P.; Payne, G.A. Beyond aflatoxin: Four distinct expression patterns and functional roles associated with Aspergillus flavus secondary metabolism gene clusters. Mol. Plant Pathol. 2010, 11, 213–226. [Google Scholar] [CrossRef] [PubMed]
- Ehrlich, K.C.; Mack, B.M. Comparison of Expression of Secondary Metabolite Biosynthesis Cluster Genes in Aspergillus flavus, A. parasiticus, and A. oryzae. Toxins 2014, 6, 1916–1928. [Google Scholar] [CrossRef]
- Saruwatari, T.; Yagishita, F.; Mino, T.; Noguchi, H.; Hotta, K.; Watanabe, K. Cytochrome P450 as Dimerization Catalyst in Diketopiperazine Alkaloid Biosynthesis. ChemBioChem 2014, 15, 656–659. [Google Scholar] [CrossRef] [PubMed]
- Cary, J.W.; Harris-Coward, P.Y.; Ehrlich, K.C.; Di Mavungu, J.D.; Malysheva, S.V.; De Saeger, S.; Dow, P.F.; Shantappa, S.; Martens, S.L.; Calvo, A.M. Functional characterization of a veA-dependent polyketide synthase gene in Aspergillus flavus necessary for the synthesis of asparasone, a sclerotium-specific pigment. Fungal Genet. Biol. 2014, 64, 25–35. [Google Scholar] [CrossRef] [PubMed]
- Cary, J.W.; Han, Z.; Yin, Y.; Lohmar, J.M.; Shantappa, S.; Harris-Coward, P.Y.; Mack, B.; Ehrlich, K.C.; Wei, Q.; Arroyo-Manzanares, N.; et al. Transcriptome Analysis of Aspergillus flavus Reveals veA -Dependent Regulation of Secondary Metabolite Gene Clusters, Including the Novel Aflavarin Cluster. Eukaryot. Cell 2015, 14, 983–997. [Google Scholar] [CrossRef] [PubMed] [Green Version]
- Cary, J.W.; Uka, V.; Han, Z.; Buyst, D.; Harris-Coward, P.Y.; Ehrlich, K.C.; Wei, Q.; Bhatnagar, D.; Dowd, P.F.; Martens, S.L.; et al. An Aspergillus flavus secondary metabolic gene cluster containing a hybrid PKS–NRPS is necessary for synthesis of the 2-pyridones, leporins. Fungal Genet. Biol. 2015, 81, 88–97. [Google Scholar] [CrossRef] [PubMed]
- Ammar, H.A.M.; Srour, A.Y.; Ezzat, S.M.; Hoseny, A.M. Identification and characterization of genes involved in kojic acid biosynthesis in Aspergillus flavus. Ann. Microbiol. 2017, 67, 691–702. [Google Scholar] [CrossRef]
- Lebar, M.D.; Cary, J.W.; Majumdar, R.; Carter-Wientjes, C.H.; Mack, B.M.; Wei, Q.; Uka, V.; De Saeger, S.; Di Mavungu, J.D. Identification and functional analysis of the aspergillic acid gene cluster in Aspergillus flavus. Fungal Genet. Biol. 2018, 116, 14–23. [Google Scholar] [CrossRef]
- Uka, V.; Cary, J.W.; Lebar, M.D.; Puel, O.; De Saeger, S.; Diana Di Mavungu, J. Chemical repertoire and biosynthetic machinery of the Aspergillus flavus secondary metabolome: A review. Compr. Rev. Food Sci. Food Saf. 2020, 19, 2797–2842. [Google Scholar] [CrossRef] [PubMed]
- Chang, P.-K.; Ehrlich, K.C.; Fujii, I. Cyclopiazonic acid biosynthesis of Aspergillus flavus and Aspergillus oryzae. Toxins 2009, 1, 74–99. [Google Scholar] [CrossRef] [PubMed] [Green Version]
- Nicholson, M.J.; Koulman, A.; Monahan, B.J.; Pritchard, B.L.; Payne, G.A.; Scott, B. Identification of two aflatrem biosynthesis gene loci in Aspergillus flavus and metabolic engineering of Penicillium paxilli to elucidate their function. Appl. Environ. Microbiol. 2009, 75, 7469–7481. [Google Scholar] [CrossRef] [PubMed] [Green Version]
- Forseth, R.R.; Amaike, S.; Schwenk, D.; Affeldt, K.J.; Hoffmeister, D.; Schroeder, F.C.; Keller, N.P. Homologous NRPS-like gene clusters mediate redundant small-molecule biosynthesis in Aspergillus flavus. Angew. Chem. Int. Ed. Engl. 2013, 52, 1590–1594. [Google Scholar] [CrossRef] [PubMed] [Green Version]
- Umemura, M.; Nagano, N.; Koike, H.; Kawano, J.; Ishii, T.; Miyamura, Y.; Kikuchi, M.; Tamano, K.; Yu, J.; Shin-ya, K.; et al. Characterization of the biosynthetic gene cluster for tribosomally synthesized cyclic peptide ustiloxin B in Aspergillus flavus. Fungal Genet. Biol. 2014, 68, 23–30. [Google Scholar] [CrossRef] [Green Version]
- Tsukui, T.; Nagano, N.; Umemura, M.; Kumagai, T.; Terai, G.; Machida, M.; Asai, K. Ustiloxins, fungal cyclic peptides, are ribosomally synthesized in Ustilaginoidea virens. Bioinformatics 2015, 31, 981–985. [Google Scholar] [CrossRef] [PubMed] [Green Version]
- Tillman, R.W.; Bean, G.A. Tentative Identification and Influence of Sterols and Dimethyl Sulfoxide (Dmso) on the Growth and Survival of Fusarium Roseum. Mycologia 1970, 62, 423–431. [Google Scholar] [CrossRef]
- Yu, J.; Fedorova, N.D.; Montalbano, B.G.; Bhatnagar, D.; Cleveland, T.E.; Bennett, J.W.; Nierman, W.C. Tight control of mycotoxin biosynthesis gene expression in Aspergillus flavus by temperature as revealed by RNA-Seq. FEMS Microbiol. Lett. 2011, 322, 145–149. [Google Scholar] [CrossRef] [Green Version]
- Zhang, F.; Guo, Z.; Zhong, H.; Wang, S.; Yang, W.; Liu, Y.; Wang, S. RNA-Seq-Based Transcriptome Analysis of Aflatoxigenic Aspergillus flavus in Response to Water Activity. Toxins 2014, 6, 3187–3207. [Google Scholar] [CrossRef] [Green Version]
- Wang, H.; Lei, Y.; Yan, L.; Cheng, K.; Dai, X.; Wan, L.; Guo, W.; Cheng, L.; Liao, B. Deep sequencing analysis of transcriptomes in Aspergillus flavus in response to resveratrol. BMC Microbiol. 2015, 15, 182. [Google Scholar] [CrossRef] [PubMed] [Green Version]
- Chang, P.-K.; Hua, S.S.; Sarreal, S.B.; Li, R.W. Suppression of Aflatoxin Biosynthesis in Aspergillus flavus By 2-Phenylethanol is associated with stimulated growth and decreased degradation of branched-chain amino acids. Toxins 2015, 7, 3887–3902. [Google Scholar] [CrossRef] [PubMed] [Green Version]
- Medina, Á.; Gilbert, M.K.; Mack, B.M.; O’Brian, G.R.; Rodríguez, A.; Bhatnagar, D.; Payne, G.; Magan, N. Interactions between water activity and temperature on the Aspergillus flavus transcriptome and aflatoxin B1 production. Int. J. Food Microbiol. 2017, 256, 36–44. [Google Scholar] [CrossRef] [Green Version]
- Chen, G.; Wang, G.Y.; Li, X.; Waters, B.; Davies, J. Enhanced Production of Microbial Metabolites in the Presence of Dimethyl Sulfoxide. J. Antibiot. 2000, 53, 1145–1153. [Google Scholar] [CrossRef] [PubMed] [Green Version]
- Bean, G.A.; Klarman, W.L.; Rambo, G.W.; Sanford, J.B. Dimethyl Sulfoxide Inhibition of Aflatoxin Synthesis by Aspergillus flavus. Phytopathology 1971, 61, 380. [Google Scholar] [CrossRef]
- Georgianna, D.R.; Payne, G.A. Genetic regulation of aflatoxin biosynthesis: From gene to genome. Fungal Genet. Biol. 2009, 46, 113–125. [Google Scholar] [CrossRef]
- Kong, Q.; Chi, C.; Yu, J.; Shan, S.; Li, Q.; Li, Q.; Guan, B.; Nierman, W.C.; Bennett, J.W. The inhibitory effect of Bacillus megaterium on aflatoxin and cyclopiazonic acid biosynthetic pathway gene expression in Aspergillus flavus. Appl. Microbiol. Biotechnol. 2014, 98, 5161–5172. [Google Scholar] [CrossRef] [PubMed]
- Nagano, N.; Umemura, M.; Izumikawa, M.; Kawano, J.; Ishii, T.; Kikuchi, M.; Tomii, K.; Kumagai, T.; Yoshimi, A.; Machida, M.; et al. Class of cyclic ribosomal peptide synthetic genes in filamentous fungi. Fungal Genet. Biol. 2016, 86, 58–70. [Google Scholar] [CrossRef] [PubMed] [Green Version]
- Umemura, M. Peptides derived from Kex2-processed repeat proteins are widely distributed and highly diverse in the Fungi kingdom. Fungal Biol. Biotechnol. 2020, 7, 11. [Google Scholar] [CrossRef]
- Umemura, M.; Koike, H.; Nagano, N.; Ishii, T.; Kawano, J.; Yamane, N.; Kozone, I.; Horimoto, K.; Shin-ya, K.; Asai, K.; et al. MIDDAS-M: Motif-independent de novo detection of secondary metabolite gene clusters through the integration of genome sequencing and transcriptome data. PLoS ONE 2013, 8, e84028. [Google Scholar] [CrossRef] [Green Version]
- Jain, S.; Keller, N.P.N. Insights to fungal biology through LaeA sleuthing. Fungal Biol. Rev. 2013, 27, 51–59. [Google Scholar] [CrossRef]
- Lv, Y.; Lv, A.; Zhai, H.; Zhang, S.; Li, L.; Cai, J.; Hu, Y. Insight into the global regulation of laeA in Aspergillus flavus based on proteomic profiling. Int. J. Food Microbiol. 2018, 284, 11–21. [Google Scholar] [CrossRef]
- Duran, R.M.; Cary, J.W.; Calvo, A.M. Production of cyclopiazonic acid, aflatrem, and aflatoxin by Aspergillus flavus is regulated by veA, a gene necessary for sclerotial formation. Appl. Microbiol. Biotechnol. 2007, 73, 1158–1168. [Google Scholar] [CrossRef] [PubMed]
- Crespo-Sempere, A.; Marín, S.; Sanchis, V.; Ramos, A.J. VeA and LaeA transcriptional factors regulate ochratoxin A biosynthesis in Aspergillus carbonarius. Int. J. Food Microbiol. 2013, 166, 479–486. [Google Scholar] [CrossRef] [PubMed]
- Dhingra, S.; Andes, D.; Calvo, A.M. VeA regulates conidiation, gliotoxin production, and protease activity in the opportunistic human pathogen Aspergillus fumigatus. Eukaryot. Cell. 2012, 11, 1531–1543. [Google Scholar] [CrossRef] [Green Version]
- Spröte, P.; Brakhage, A.A. The light-dependent regulator velvet A of Aspergillus nidulans acts as a repressor of the penicillin biosynthesis. Arch. Microbiol. 2007, 188, 69–79. [Google Scholar] [CrossRef] [PubMed]
- Sarikaya-Bayram, Ö.; Palmer, J.M.; Keller, N.P.; Braus, G.H.; Bayram, Ö. One Juliet and four Romeos: VeA and its methyltransferases. Front. Microbiol. 2015, 6, 1. [Google Scholar] [CrossRef] [PubMed] [Green Version]
- Ramamoorthy, V.; Dhingra, S.; Kincaid, A.; Shantappa, S.; Feng, X.; Calvo, A.M. The putative C2H2 transcription factor MtfA is a novel regulator of secondary metabolism and morphogenesis in Aspergillus nidulans. PLoS ONE 2013, 16, e74122. [Google Scholar] [CrossRef] [PubMed] [Green Version]
- Zhuang, Z.; Lohmar, J.M.; Satterlee, T.; Cary, J.W.; Calvo, A.M. The Master Transcription Factor mtfA Governs Aflatoxin Production, Morphological Development and Pathogenicity in the Fungus Aspergillus flavus. Toxins 2016, 8, 29. [Google Scholar] [CrossRef]
- Pihet, M.; Vandeputte, P.; Tronchin, G.; Renier, G.; Saulnier, P.; Georgeault, S.; Mallet, R.; Chabasse, D.; Symoens, F.; Bouchara, J.P. Melanin is an essential component for the integrity of the cell wall of Aspergillus fumigatus conidia. BMC Microbiol. 2009, 9, 177. [Google Scholar] [CrossRef]
- Pal, A.K.; Gajjar, D.U.; Vasavada, A.R. DOPA and DHN pathway orchestrate melanin synthesis in Aspergillus species. Med. Mycol. 2014, 52, 10–18. [Google Scholar] [CrossRef] [Green Version]
- Dzhavakhiya, V.G.; Voinova, T.M.; Popletaeva, S.B.; Statsyuk, N.V.; Limantseva, L.A.; Shcherbakova, L.A. Effect of Various Compounds Blocking the Colony Pigmentation on the Aflatoxin B1 Production by Aspergillus flavus. Toxins 2016, 8, 313. [Google Scholar] [CrossRef] [PubMed]
- Calvo, A.M.; Wilson, R.A.; Bok, J.W.; Keller, N.P. Relationship between secondary metabolism and fungal development. Microbiol. Mol. Biol. Rev. 2002, 66, 447–459. [Google Scholar] [CrossRef] [PubMed] [Green Version]
- Wu, M.Y.; Mead, M.E.; Lee, M.K.; Ostrem Loss, E.M.; Kim, S.C.; Rokas, A.; Yu, J.H. Systematic Dissection of the Evolutionarily Conserved WetA Developmental Regulator across a Genus of Filamentous Fungi. mBio 2018, 9, e01130-18. [Google Scholar] [CrossRef] [Green Version]
- Wu, M.Y.; Mead, M.E.; Lee, M.K.; Neuhaus, G.F.; Adpressa, D.A.; Martien, J.I.; Son, Y.E.; Moon, H.; Amador-Noguez, D.; Han, K.H.; et al. Transcriptomic, Protein-DNA Interaction, and Metabolomic Studies of VosA, VelB, and WetA in Aspergillus nidulans Asexual Spores. mBio 2021, 12, e03128-20. [Google Scholar] [CrossRef]
- Suzuki, S.; Bayram, Ö.S.; Bayram, Ö.; Braus, G.H. conF and conJ contribute to conidia germination and stress response in the filamentous fungus Aspergillus nidulans. Fungal Genet. Biol. 2013, 56, 42–53. [Google Scholar] [CrossRef] [Green Version]
- Millar, L.J.; Heck, I.S.; Sloan, J.; Kana’n, G.J.; Kinghorn, J.R.; Unkles, S.E. Deletion of the cnxE gene encoding the gephyrin-like protein involved in the final stages of molybdenum cofactor biosynthesis in Aspergillus nidulans. Mol. Genet. Genom. 2001, 266, 445–453. [Google Scholar] [CrossRef] [PubMed]
- Unkles, S.E.; Heck, I.S.; Appleyard, M.V.; Kinghorn, J.R. Eukaryotic molybdopterin synthase. Biochemical and molecular studies of Aspergillus nidulans cnxG and cnxH mutants. J. Biol. Chem. 1999, 274, 19286–19293. [Google Scholar] [CrossRef] [PubMed] [Green Version]
- Schwarz, G.; Mendel, R.R.; Ribbe, M.W. Molybdenum cofactors, enzymes and pathways. Nature 2009, 460, 839–847. [Google Scholar] [CrossRef]
- Rabie, C.J.; Meyer, C.J.; van Heerden, L.; Lübben, A. Inhibitory effect of molybdenum and vanadium salts on aflatoxin B1 synthesis by Aspergillus flavus. Can. J. Microbiol. 1981, 27, 962–967. [Google Scholar] [CrossRef] [PubMed]

| Gene ID | Description | Common Name | Fold Change | q-Value | Fold Change | q-Value |
|---|---|---|---|---|---|---|
| AFLA_066460 | developmental regulator AflYf/VeA | veA | 1.24 | 6.75 × 10−4 | 1.77 | 2.98 × 10−33 |
| AFLA_091490 | C2H2 finger domain protein, putative | mtfA | - | - | 1.26 | 4.30 × 10−3 |
| AFLA_033290 | regulator of secondary metabolism LaeA | laeA | - | - | −1.55 | 2.85 × 10−12 |
| AFLA_101920 | conserved hypothetical protein | fluG | - | - | 1.24 | 6.83 × 10−3 |
| AFLA_134030 | extracellular developmental signal biosynthesis protein FluG | flbA | - | - | 1.44 | 1.05 × 10−5 |
| AFLA_131490 | hypothetical protein | flbB | - | - | −1.20 | 1.77 × 10−3 |
| AFLA_137320 | C2H2 conidiation transcription factor FlbC | flbC | - | - | −1.62 | 1.96 × 10−4 |
| AFLA_080170 | MYB family conidiophore development protein FlbD, putative | flbD | - | - | −1.42 | 4.71v10−5 |
| AFLA_082850 | C2H2 type conidiation transcription factor BrlA | brlA | - | - | −1.14 | 4.76 × 10−2 |
| AFLA_026900 | developmental regulator VosA | vosA | - | - | 2.21 | 9.16 × 10−34 |
| AFLA_029620 | transcription factor AbaA | abaA | - | - | −1.22 | 1.13 × 10−2 |
| AFLA_052030 | developmental regulatory protein WetA | wetA | - | - | 1.49 | 1.93 × 10−8 |
| AFLA_044790 | conidiation-specific proteins | - | - | 3.63 | 2.36 × 10−16 | |
| AFLA_044800 | conidiation specific-protein Con-6 | ConF | - | - | 4.95 | 2.11 × 10−42 |
| AFLA_083110 | conidiation-specific protein Con-10 | ConJ | - | - | 4.53 | 4.08 × 10−37 |
| AFLA_014260 | conidial hydrophobin RodB/HypB | rodB | - | - | −1.55 | 9.04 × 10−7 |
| AFLA_060780 | conidial hydrophobin dewA | dewA | 2.58 | 3.05 × 10−3 | ||
| AFLA_006180 | conidial pigment biosynthesis oxidase Arb2/brown2 | arb2 | - | - | 1.45 | 1.10 × 10−5 |
| AFLA_006170 | polyketide synthetase PksP | pksP/alb1/wA | 1.83 | 3.47 × 10−12 | 5.03 | 9.57 × 10−90 |
| AFLA_075640 | pigment biosynthesis protein Ayg1 | ayg1 | - | - | 2.26 | 7.39 × 10−14 |
Publisher’s Note: MDPI stays neutral with regard to jurisdictional claims in published maps and institutional affiliations. |
© 2021 by the authors. Licensee MDPI, Basel, Switzerland. This article is an open access article distributed under the terms and conditions of the Creative Commons Attribution (CC BY) license (https://creativecommons.org/licenses/by/4.0/).
Share and Cite
Costes, L.H.; Lippi, Y.; Naylies, C.; Jamin, E.L.; Genthon, C.; Bailly, S.; Oswald, I.P.; Bailly, J.-D.; Puel, O. The Solvent Dimethyl Sulfoxide Affects Physiology, Transcriptome and Secondary Metabolism of Aspergillus flavus. J. Fungi 2021, 7, 1055. https://doi.org/10.3390/jof7121055
Costes LH, Lippi Y, Naylies C, Jamin EL, Genthon C, Bailly S, Oswald IP, Bailly J-D, Puel O. The Solvent Dimethyl Sulfoxide Affects Physiology, Transcriptome and Secondary Metabolism of Aspergillus flavus. Journal of Fungi. 2021; 7(12):1055. https://doi.org/10.3390/jof7121055
Chicago/Turabian StyleCostes, Laura H., Yannick Lippi, Claire Naylies, Emilien L. Jamin, Clémence Genthon, Sylviane Bailly, Isabelle P. Oswald, Jean-Denis Bailly, and Olivier Puel. 2021. "The Solvent Dimethyl Sulfoxide Affects Physiology, Transcriptome and Secondary Metabolism of Aspergillus flavus" Journal of Fungi 7, no. 12: 1055. https://doi.org/10.3390/jof7121055
APA StyleCostes, L. H., Lippi, Y., Naylies, C., Jamin, E. L., Genthon, C., Bailly, S., Oswald, I. P., Bailly, J.-D., & Puel, O. (2021). The Solvent Dimethyl Sulfoxide Affects Physiology, Transcriptome and Secondary Metabolism of Aspergillus flavus. Journal of Fungi, 7(12), 1055. https://doi.org/10.3390/jof7121055

